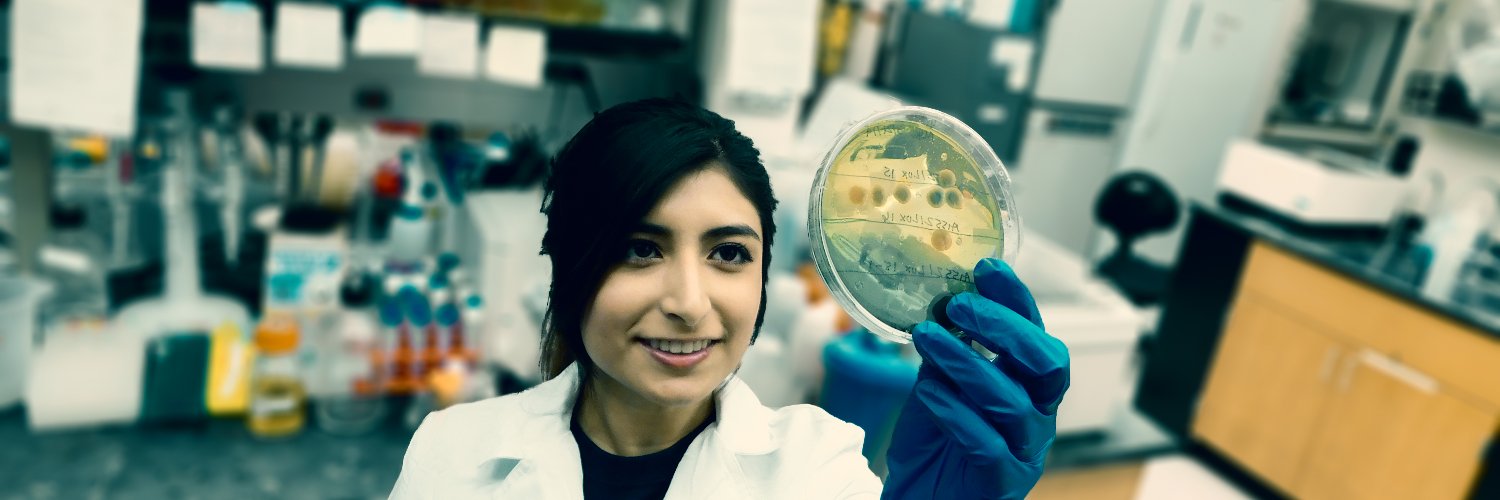
UT San Antonio Molecular Microbiology & Immunology banner

UT San Antonio Molecular Microbiology & Immunology retweetledi

Join us next week on March 26th in the Loeffler Room (BSB 3.03.02) for our Spring Neuroscience Symposium hosted by Dr. Francesco Savelli (NDRB Dept.). Open to all, see yall there!
@UTSAResearch
@UTSASciences
@UTSANeuroDevRe1

English